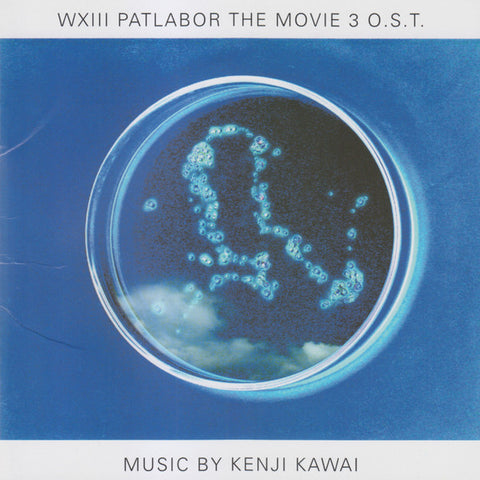

Kenji Kawai
WXIII Patlabor The Movie 3
Release Date: 2002
Format: Pre-Owned CD
Label: Pioneer Records
Catalog Number: 5200-2
1 Title 2:22
2 Something Beauty 1:15
3 Their Daily Lives 2:10
4 Inpatiants 1:09
5 Her Solitude 1:24
6 Darkness Besides Airport 1:16
7 WXIII 5:02
8 At The Institute 1:53
9 Invisible Uneasiness 2:05
10 The Self-Defense Forces 1:47
11 Detectives 2:35
12 The Other Side Of Her 1:52
13 Serious Decision 5:39
14 Ryujin 2:41
15 Sonata Fur Klavier Nr.8 Pathetique Adagio Cantabile 5:40
16 The Last Rain 1:40
17 Ending 5:15






